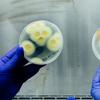
hands holding up two petri dishes, one filled with white and yellow spores and the other with a blooming yellow and orange spore

Ira Flatow appears in the following:
Valley Fever, Citizen Science Month Finale
Friday, April 24, 2020
To doctors, valley fever is a medical mystery. Now, the disease is spreading. Plus, you can help scientists navigate datasets gathered from anti-slavery activists and images of Mars.
Science Friday News Roundup 4/24/20
Friday, April 24, 2020
The first COVID-19 death in the U.S. was three weeks before we initially thought.
Science Friday News Roundup 4/17/20
Friday, April 17, 2020
COVID-19 is having a disproportionate impact on minority populations who are exposed to polluted air.
COVID-19 Factcheck, Digital Earth Day, City Nature Challenge, Ancient Antarctic
Friday, April 17, 2020
Virologist Angela Rasmussen breaks down the concept of reactivation of the coronavirus in recovered patients. Plus, due to COVID-19, the 50th Earth Day will be digital.
Degrees of Change: Climate Anxiety and Depression
Friday, April 17, 2020
You aren’t alone in grieving the climate crisis. We talk about turning feelings of loss into action for the climate.
Spring Sounds, Luxury Ostrich Eggs, ISeeChange
Friday, April 10, 2020
Scientists talk about how to find glory in the birds, bees, and other joys of spring safely. Plus, deciphering the ornate status symbols of Bronze and Iron age elite.
Healthcare Ripple Effects, Resilient Flowers, Cancer Detection
Friday, April 10, 2020
The COVID-19 crisis is having ripple effects on other parts of the healthcare system. And researchers are creating a device to sense odors from cancer cells, using dogs’ keen noses.
DIY Masks, Neanderthal Diet, Symbiotic Worms
Friday, April 03, 2020
Due to shortages of crucial supplies, healthcare workers ask volunteers to make medical masks. Plus, why dining from the sea might knock down another theory of Neanderthal inferiority.
COVID-19 Supplies Shortage, Citizen Science Month, Mercury Discovery
Friday, April 03, 2020
Try citizen science projects that let you explore the universe or your town’s water quality—while staying home. Plus, Mercury may have the basic chemical building blocks of life.
Squid Lighting, Tongue Microbiome, Invasive Herbivores
Friday, March 27, 2020
New research finds how Humboldt squid use their skin color and bioluminescence to communicate to one another. Plus, scientists map the microbiome of your tongue.
COVID Near You Citizen Science, Fact-Check Your Feed
Friday, March 27, 2020
How citizen scientists can help the CDC track the spread of the coronavirus in the U.S. Plus, taking a closer look at some of the viral stories about the coronavirus.
Farmers’ Stress, Tiny Dino-Bird Discovery
Friday, March 13, 2020
In the 1980s, farmers were pushed to the brink of suicide. Today, it might be worse. Plus, a discovery of tracks of Jurassic carnivorous dinosaurs and a stegosaurus in Scotland.
Coronavirus: Washing and Sanitizing, Science Diction, New HIV PrEP Drugs
Friday, March 13, 2020
Coronavirus is easy to kill with soap and water. How it works and why it matters for everyone. Plus, a new podcast from Science Friday looks at the scientific backstories behind words.
Astronaut Training, Marsquakes, Whale Migration
Friday, March 06, 2020
NASA is accepting applications for a new class of astronaut candidates. Do you have what it takes? Plus, what studying seismic activity on Mars tells us about the red planet.
Coronavirus Genetics, Prosthetic Hands
Friday, March 06, 2020
Surgery and AI are teaming up to make artificial limbs more intuitive and user-friendly. Plus, scientists sequenced the genome of the new coronavirus from patients in Washington state.
Coronavirus Preparedness, Facebook’s History
Friday, February 28, 2020
Why protecting healthcare workers will be key in dealing with the coronavirus. Plus, journalist Steven Levy chronicles Facebook from college room-social media site to tech powerhouse.
Degrees of Change: Building Materials
Friday, February 28, 2020
How the world of building materials—wood, steel and concrete—is responding to climate change.
Coronavirus Update, Genuine Fakes, Neanderthal News
Friday, February 21, 2020
Science historian Lydia Pyne on how “genuine fakes” live in a gray area. Plus, a new Neanderthal find in Kurdistan’s Shanidar Cave could provide new insights into ancient culture.
Ask A Dentist
Friday, February 21, 2020
We talk with dental experts about how your gums affect your heart, frontiers in cavity prevention, and why the future of dentistry is personal.
Building A Ghost Heart, The Effect Of Big Tech
Friday, February 14, 2020
How massive tech companies have grown to resemble nation states. Plus, scientists are making hybrid mechanical animal hearts in the hopes of finding alternate transplantable organs.